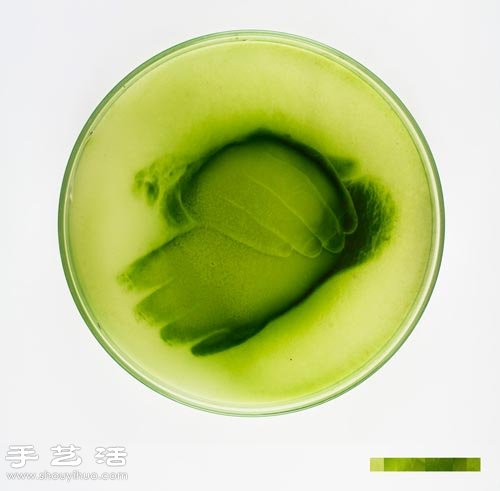
利用藻类微生物DIY制作创意海藻画

巴黎艺术家Lia giraud利用自己培养的藻类生物DIY出的创意绘画,图案内容包括人物肖像、白炽灯泡及生活场景等。
他将放有藻类微生物的培养皿放到图片上方,微生物们由于生物习性的不同,会自动根据图片上的不同亮度聚集,进而呈现出不同密度,历经四天后一幅漂亮的创意海藻画便诞生了。




未经允许不得转载:匠能资讯 » 利用藻类微生物DIY制作创意海藻画

匠能资讯
巴黎艺术家Lia giraud利用自己培养的藻类生物DIY出的创意绘画,图案内容包括人物肖像、白炽灯泡及生活场景等。
他将放有藻类微生物的培养皿放到图片上方,微生物们由于生物习性的不同,会自动根据图片上的不同亮度聚集,进而呈现出不同密度,历经四天后一幅漂亮的创意海藻画便诞生了。

未经允许不得转载:匠能资讯 » 利用藻类微生物DIY制作创意海藻画